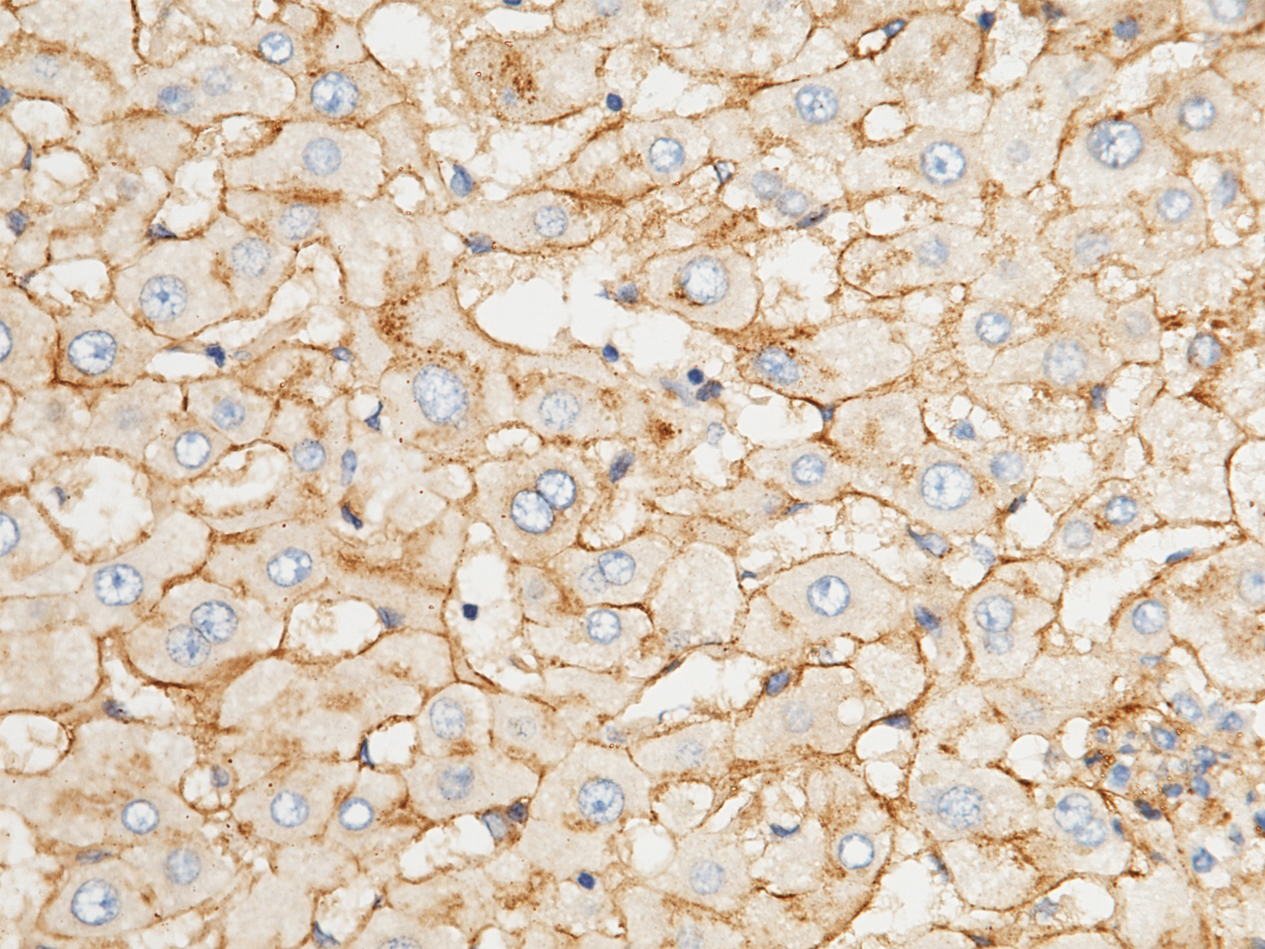
解锁阿尔茨海默病（AD）靶点密码，开启靶向治疗新篇章

前 言
阿尔茨海默病(AD)是一种严重的神经退行性疾病,多发于高龄人群,主要表现为记忆、思维、分析判断、视空间辨认、情绪等障碍。从实验室到临床应用的过程充满挑战。阿尔茨海默症新型疗法的开发主要聚焦于靶向Aβ、tau、神经炎症和突触保护等。AD相关重组蛋白在推动药物发现和破译靶点相互作用中发挥重要作用。义翘神州提供AD相关的高品质药物靶点重组蛋白及抗体产品,支持AD疾病诊断研究和药物研发。
01 AD相关靶点
AD的病理变化包括胞外淀粉样蛋白β(Aβ)沉积形成淀粉样斑块、Tau蛋白过度磷酸化形成神经元纤维缠结(NFT)、神经炎症、神经元丢失、突触障碍等。AD的常见生物标志物包括淀粉样前体蛋白(APP)、微管相关蛋白(Tau)、NGF、CASP9、CLU、AGER、DPYSL2、PNMT、BDNF、GSK3B、ApoE、GLP-1R、BACE1等。
这些生物标志物在AD生理和病理过程发挥着关键作用。比如,NGF、DPYSL2维持神经细胞的生长。CASP9对细胞程序性死亡(凋亡)和组织稳态至关重要。CLU、GSK3B可调节各种细胞功能。AGER在病理状态下会诱发炎症和氧化应激。PNMT与压力相关激素的合成相关。BDNF支持神经元的存活和可塑性。BACE1与AD中Aβ的产生相关,是AD治疗的重要靶点之一。GLP1R激动剂已被证明在抗神经炎症、减轻氧化应激和神经营养等方面发挥重要作用,已成为治疗AD的潜在药物。
02 AD蛋白在研究中的应用
高品质重组蛋白(如APP、Tau、ApoE等)已应用于AD药物研发,能够促进机理研究和临床前评估,从而推动AD创新疗法的开发。Gao团队利用重组GSK-3β蛋白(货号:
10044-H07B)验证了GSK-3β与PKG之间的相互作用,发现Icariside II通过干扰PKG/GSK-3β/自噬轴减轻脑损伤。Endicott团队利用重组Tau蛋白(货号:
10058-H07E)和蛋白酶抑制剂处理溶酶体,发现经buparlisib或pictilisib处理的小鼠肝溶酶体对CMA底物Tau的吸收增强。Sperling团队利用重组AChE蛋白(货号:
50543-M08H)研究发现与laminin-1结合会导致神经元生长。Zhang团队利用重组APP或BACE1蛋白(义翘神州)研究发现与氧化石墨烯(GO)纳米颗粒的相互作用,可降低小鼠体内的Aβ水平并改善其记忆力。Vojdani团队利用重组β-NGF和BDNF蛋白(义翘神州)发现与抗Aβ-42肽抗体高度反应。
用于表面等离子体共振SPR检测
将不同浓度的PKG与GSK-3β(货号:
10044-H07B,义翘神州)结合,利用表面等离子体共振(SPR)技术测定结合亲和力。Doi: 10.1111/bph.14912
用于CMA底物检测

与对照组相比,经buparlisib或pictilisib处理的小鼠肝溶酶体对CMA底物Tau(货号:
10058-H07E,义翘神州)的摄取增加,GFAP磷酸化减少。Doi: 10.1083/jcb.202001031
用于免疫染色

抗 (His)6 Tag 抗体(绿色)对 (His)6 Tag E6-AChE (货号:
50543-M08H,义翘神州)处理过的 R28 细胞进行免疫染色。细胞核用 DAPI(蓝色)染色。Doi:10.1371/journal.pone.0036683
用于WB检测

通过WB检测GO/BGO 与 APP或BACE1(义翘神州)的相互作用。S 和 P 分别指沉淀得到的上清液和沉淀颗粒。Doi: 10.7150/thno.50616
用于ELISA检测

通过ELISA方法测定对照组和 AD 血清中的抗体水平。针对各种蛋白质和肽的 IgG 抗体,包括 β-NGF 和 BDNF(义翘神州),都与 AD 有关。Doi: 10.1155/2018/1672568
✦义翘神州AD特色产品
义翘神州的产品已支持多篇文章发表在国内外学术期刊,涉及到的产品有重组蛋白、抗体、ELISA试剂、基因等。
Human GLP1R Protein (His & AVI Tag) (Cat: 13944-H49H-B)
Purity: ≥95% determined by SEC-HPLC and SDS-PAGE.
Human GSK3B Protein (His Tag) (Cat: 10044-H07B)
助力4篇文章发表

Immobilized His-GSK3B can bind to biotinylated human HG3C-CTNNB1
Anti-Clusterin Antibody, Mouse mAb (Cat: 11297-MM01)
应用:WB、ELISA、FCM、ICC/IF

Immunofluorescence staining of Human CLU in Hela cells.
Anti-ApoE Antibody, Rabbit pAb (Cat: 10817-RP02)
助力4篇文章发表,应用:ELISA、IHC-P
Immunochemical staining of human APOE in human liver.
更多AD相关重组蛋白产品
更多AD相关抗体产品
| 货号 | 靶点 | 克隆性 | 应用 |
|---|
| 11050-R711 | NGF | Neutralizing | Neutralization |
| 102185-T38 | Caspase-9 | Rabbit pAb | WB, ICC/IF, IP |
| 10064-RO27-F | BACE1 | Rabbit mAb | FCM |
| 11297-R210 | Clusterin | Rabbit mAb | lHC-P |
| 11629-T24 | RAGE | Rabbit pAb | ELISA, lHC-P |
| 109663-T08 | DpYSL2 | Rabbit pAb | lHC-P |
| 204179-T36 | PNMT | Rabbit pAb | WB, IP |
| 50650-T38 | GSK3B | Rabbit pAb | WB, ICC/IF, IP |
| 10817-RPO1 | ApoE | Rabbit pAb | ELISA |
| 12093-T62 | alpha-Synuclein | Rabbit pAb | WB, ELISA, 1HC-P, ICC/IF, IP |
【参考文献】
1. Husna Ibrahim, N. et al. Pharmacotherapy of Alzheimer’s Disease: Seeking Clarity in a Time of Uncertainty. Frontiers in Pharmacology vol. 11 Preprint at https://doi.org/10.3389/fphar.2020.00261 (2020).
2. Hansson, O. et al. The Alzheimer’s Association appropriate use recommendations for blood biomarkers in Alzheimer’s disease. Alzheimer’s and Dementia vol. 18 2669–2686 Preprint at https://doi.org/10.1002/alz.12756 (2022).
3. Tahami Monfared, et al. Alzheimer’s Disease: Epidemiology and Clinical Progression. Neurology and Therapy vol. 11 553–569 Preprint at https://doi.org/10.1007/s40120-022-00338-8 (2022).
4. Seibert, M. et al. Efficacy and safety of pharmacotherapy for Alzheimer’s disease and for behavioural and psychological symptoms of dementia in older patients with moderate and severe functional impairments: a systematic review of controlled trials. Alzheimers Res Ther 13, (2021).
5. Bai, B. et al. Proteomic landscape of Alzheimer’s Disease: novel insights into pathogenesis and biomarker discovery. Molecular Neurodegeneration vol. 16 Preprint at https://doi.org/10.1186/s13024-021-00474-z (2021).
6. Sperling, et al. Mouse acetylcholinesterase enhances neurite outgrowth of rat R28 cells through interaction with laminin-1. PLoS One 7, (2012).
7. van Dyck, C. H. et al. Lecanemab in Early Alzheimer’s Disease. New England Journal of Medicine 388, 9–21 (2023).
8. Vaz, M., et al. Role of Aducanumab in the Treatment of Alzheimer’s Disease: Challenges and Opportunities. Clinical Interventions in Aging vol. 17 797–810 Preprint at https://doi.org/10.2147/CIA.S325026 (2022).
9. Hampel, H. et al. The Amyloid-β Pathway in Alzheimer’s Disease. Molecular Psychiatry vol. 26 5481–5503 Preprint at https://doi.org/10.1038/s41380-021-01249-0 (2021).
10. Husain, M. A., Laurent, B. & Plourde, M. APOE and Alzheimer’s Disease: From Lipid Transport to Physiopathology and Therapeutics. Frontiers in Neuroscience vol. 15 Preprint at https://doi.org/10.3389/fnins.2021.630502 (2021).
11. Milà-Alomà, M. et al. Plasma p-tau231 and p-tau217 as state markers of amyloid-β pathology in preclinical Alzheimer’s disease. Nat Med 28, 1797–1801 (2022).
12. Li, Q. X. et al. GLP-1 and Underlying Beneficial Actions in Alzheimer’s Disease, Hypertension, and NASH. Frontiers in Endocrinology vol. 12 Preprint at https://doi.org/10.3389/fendo.2021.721198 (2021).
13. Amadoro, G. et al. Nerve Growth Factor-Based Therapy in Alzheimer’s Disease and Age-Related Macular Degeneration. Frontiers in Neuroscience vol. 15 Preprint at https://doi.org/10.3389/fnins.2021.735928 (2021).
14. Rohn, et al. Immunohistochemical analysis of caspase expression in the brains of individuals with obesity or overweight. Neurobiology of disease 11(2), 341-354 (2002).
15. 1Foster, et al. Clusterin in Alzheimer’s disease: Mechanisms, genetics, and lessons from other pathologies. Frontiers in Neuroscience vol. 13 Preprint at https://doi.org/10.3389/fnins.2019.00164 (2019).
16. Bennet, A. M. et al. Genetic association of sequence variants near AGER/NOTCH4 and dementia. Journal of Alzheimer’s Disease 24, 475–484 (2011).
17. Noura, M. et al. Pivotal role of DPYSL2A in KLF4-mediated monocytic differentiation of acute myeloid leukemia cells. Sci Rep 10, (2020).
18. Henjum, K. et al. Cerebrospinal fluid catecholamines in Alzheimer’s disease patients with and without biological disease. Transl Psychiatry 12, (2022).
19. Lauretti, E., Dincer, O. & Praticò, D. Glycogen synthase kinase-3 signaling in Alzheimer’s disease. Biochimica et Biophysica Acta - Molecular Cell Research vol. 1867 Preprint at https://doi.org/10.1016/j.bbamcr.2020.118664 (2020).
20. Gao, J. et al. Icariside II, a phosphodiesterase 5 inhibitor, attenuates cerebral ischaemia/reperfusion injury by inhibiting glycogen synthase kinase-3β-mediated activation of autophagy. Br J Pharmacol 177, 1434–1452 (2020).
21. Hampel, H. et al. The β-Secretase BACE1 in Alzheimer’s Disease. Biological Psychiatry vol. 89 745–756 Preprint at https://doi.org/10.1016/j.biopsych.2020.02.001 (2021).
22. Du, H., et al. The mechanism and efficacy of GLP-1 receptor agonists in the treatment of Alzheimer’s disease. Frontiers in Endocrinology 13, 1033479 (2022).
23. Endicott, et al. Inhibition of class I PI3K enhances chaperone-mediated autophagy. J Cell Biol 219, (2020).
24. Zhang, J. et al. Graphene oxide improves postoperative cognitive dysfunction by maximally alleviating amyloid beta burden in mice. Theranostics 10, 11908–11920 (2020).
25. Vojdani, A. & Vojdani, E. Amyloid-Beta 1-42 Cross-Reactive Antibody Prevalent in Human Sera May Contribute to Intraneuronal Deposition of A-Beta-P-42. Int J Alzheimers Dis 2018, (2018).